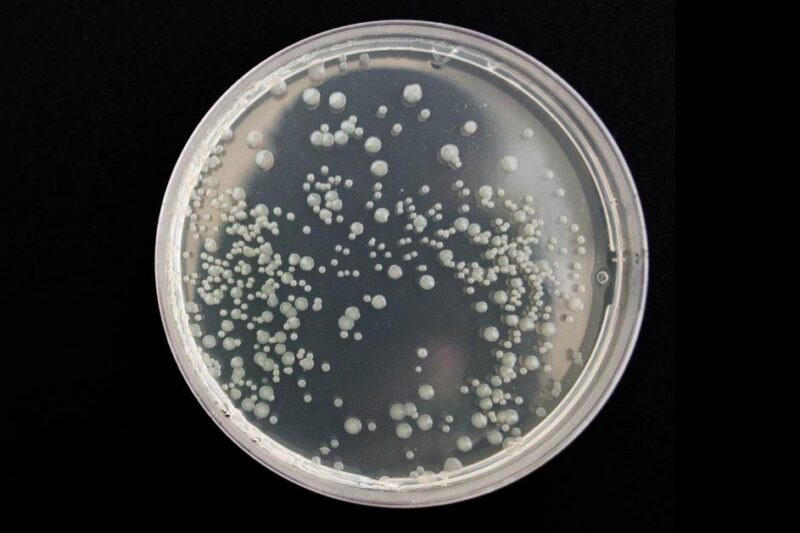
Poultry Chicken Bronchitis

Microflora in the Digestive Tract
Many problems with the digestion system are a result of beneficial microflora being out of balance. When that happens, the digestive tract can be overrun with many foreign organisms and cause diarrhea which leads to dehydration and malnutrition. When a chick is born in nature, its digestive tract is sterile. So, chicks actually get this…